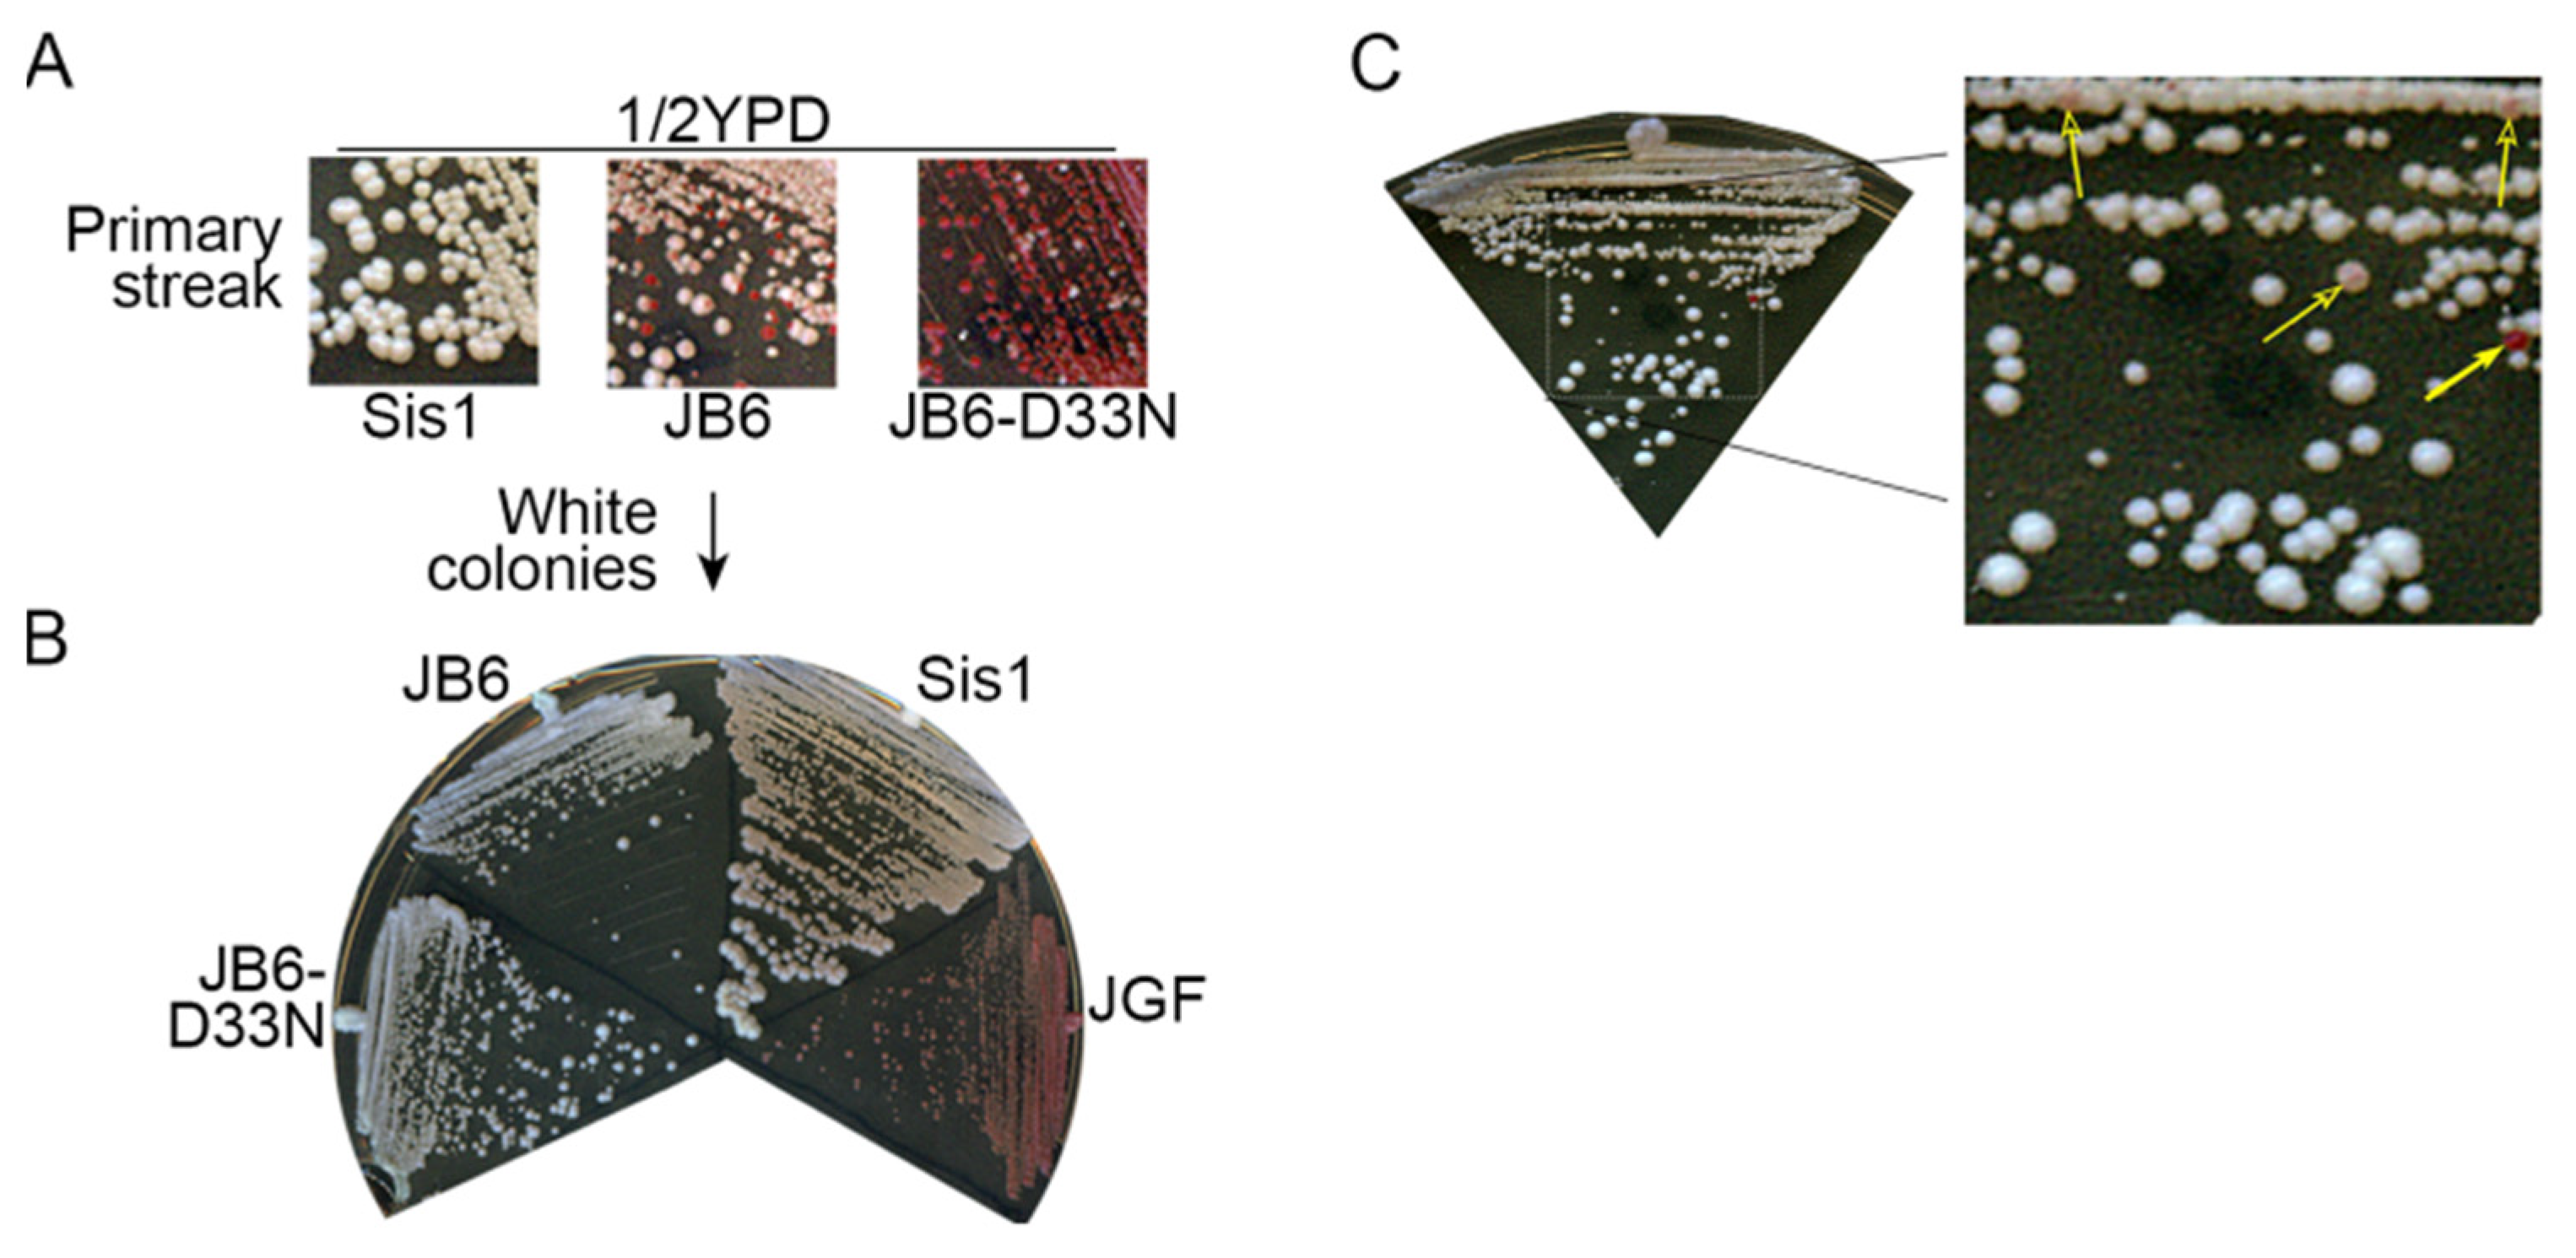
Biology 11 01846 g002 Biology 11 01846 g002

Human J-Domain Protein DnaJB6 Protects Yeast from [PSI+] Prion Toxicity
Abstract
Simple Summary
Abstract
1. Introduction
1.1. Yeast Prions Are Infectious Amyloids
1.2. [PSI+] Prions Depend on Protein Chaperones for Replication and Have Latent Toxicity
1.3. Human JDP DnaJB6 Protects Yeast from Amyloid Toxicity and Cures Yeast of Prions
2. Materials and Methods
2.1. Yeast Strains, Plasmids, and Growth Conditions
2.2. Monitoring Prions
2.3. Plasmid Shuffle
2.4. Growth Rates
2.5. Western Blots for Sis1 Abundance
2.6. Fluorescence Microscopy
3. Results
3.1. DnaJB6b Protects Yeast from Toxicity of [PSI+]S Prions
3.2. DnaJB6b Prevents Hyper-Aggregation of Sup35 When Sis1 Is Depleted
3.3. NGMC Can Be Recovered from Large Prion Aggregates
4. Discussion
5. Conclusions
Supplementary Materials
Author Contributions
Funding
Institutional Review Board Statement
Informed Consent Statement
Data Availability Statement
Acknowledgments
Conflicts of Interest
References
- Wickner, R.B. [URE3] as an altered ure2 protein: Evidence for a prion analog in Saccharomyces Cerevisiae. Science 1994, 264, 566–569. [Google Scholar] [CrossRef]
- Tanaka, M.; Chien, P.; Naber, N.; Cooke, R.; Weissman, J.S. Conformational variations in an infectious protein determine prion strain differences. Nature 2004, 428, 323–328. [Google Scholar] [CrossRef]
- Jung, G.; Jones, G.; Wegrzyn, R.D.; Masison, D.C. A role for cytosolic hsp70 in yeast [PSI+] prion propagation and [PSI+] as a cellular stress. Genetics 2000, 156, 559–570. [Google Scholar] [CrossRef]
- Uptain, S.M.; Sawicki, G.J.; Caughey, B.; Lindquist, S. Strains of [PSI+] are distinguished by their efficiencies of prion-mediated conformational conversion. EMBO J. 2001, 20, 6236–6245. [Google Scholar] [CrossRef]
- Chernoff, Y.O.; Lindquist, S.L.; Ono, B.; Inge-Vechtomov, S.G.; Liebman, S.W. Role of the chaperone protein hsp104 in propagation of the yeast prion-like factor [psi+]. Science 1995, 268, 880–884. [Google Scholar] [CrossRef] [PubMed]
- Reidy, M.; Miot, M.; Masison, D.C. Prokaryotic chaperones support yeast prions and thermotolerance and define disaggregation machinery interactions. Genetics 2012, 192, 185–193. [Google Scholar] [CrossRef] [PubMed]
- Luke, M.M.; Sutton, A.; Arndt, K.T. Characterization of Sis1, a Saccharomyces cerevisiae homologue of bacterial dnaj proteins. J. Cell Biol. 1991, 114, 623–638. [Google Scholar] [CrossRef] [PubMed]
- Sondheimer, N.; Lopez, N.; Craig, E.A.; Lindquist, S. The role of sis1 in the maintenance of the [RNQ+] prion. EMBO J. 2001, 20, 2435–2442. [Google Scholar] [CrossRef]
- Lopez, N.; Aron, R.; Craig, E.A. Specificity of class ii hsp40 sis1 in maintenance of yeast prion [RNQ+]. Mol. Biol. Cell 2003, 14, 1172–1181. [Google Scholar] [CrossRef]
- Aron, R.; Higurashi, T.; Sahi, C.; Craig, E.A. J-protein co-chaperone sis1 required for generation of [RNQ+] seeds necessary for prion propagation. EMBO J. 2007, 26, 3794–3803. [Google Scholar] [CrossRef]
- Higurashi, T.; Hines, J.K.; Sahi, C.; Aron, R.; Craig, E.A. Specificity of the J-protein Sis1 in the propagation of 3 yeast prions. Proc. Natl. Acad. Sci. USA 2008, 105, 16596–16601. [Google Scholar] [CrossRef]
- McGlinchey, R.P.; Kryndushkin, D.; Wickner, R.B. Suicidal [PSI+] is a lethal yeast prion. Proc. Natl. Acad. Sci. USA 2011, 108, 5337–5341. [Google Scholar] [CrossRef] [PubMed]
- Urakov, V.N.; Mitkevich, O.V.; Dergalev, A.A.; Ter-Avanesyan, M.D. The Pub1 and Upf1 proteins act in concert to protect yeast from toxicity of the [PSI+] prion. Int. J. Mol. Sci. 2018, 19, 3663. [Google Scholar] [CrossRef]
- Wickner, R.B.; Edskes, H.K.; Son, M.; Wu, S. Anti-prion systems block prion transmission, attenuate prion generation, cure most prions as they arise and limit prion-induced pathology in Saccharomyces cerevisiae. Biology 2022, 11, 1266. [Google Scholar] [CrossRef] [PubMed]
- Bandyopadhyay, A.; Sannigrahi, A.; Chattopadhyay, K. Membrane composition and lipid to protein ratio modulate amyloid kinetics of yeast prion protein. RSC Chem. Biol. 2021, 2, 592–605. [Google Scholar] [CrossRef] [PubMed]
- Kirkland, P.A.; Reidy, M.; Masison, D.C. Functions of yeast Hsp40 chaperone Sis1p dispensable for prion propagation but important for prion curing and protection from prion toxicity. Genetics 2011, 188, 565–577. [Google Scholar] [CrossRef]
- Harris, J.M.; Nguyen, P.P.; Patel, M.J.; Sporn, Z.A.; Hines, J.K. Functional diversification of Hsp40: Distinct J-protein functional requirements for two prions allow for chaperone-dependent prion selection. PLoS Genet. 2014, 10, e1004510. [Google Scholar] [CrossRef][Green Version]
- Stein, K.C.; True, H.L. Structural variants of yeast prions show conformer-specific requirements for chaperone activity. Mol. Microbiol. 2014, 93, 1156–1171. [Google Scholar] [CrossRef]
- Kumar, J.; Reidy, M.; Masison, D.C. Yeast j-protein Sis1 prevents prion toxicity by moderating depletion of prion protein. Genetics 2021, 219. [Google Scholar] [CrossRef]
- Li, J.; Wu, Y.; Qian, X.; Sha, B. Crystal structure of yeast Sis1 peptide-binding fragment and Hsp70 Ssa1 c-terminal complex. Biochem. J. 2006, 398, 353–360. [Google Scholar] [CrossRef]
- Hageman, J.; Rujano, M.A.; Waarde, M.A.v.; Kakkar, V.; Dirks, R.P.; Govorukhina, N.; Oosterveld-Hut, H.M.J.; Lubsen, N.H.; Kampinga, H.H. A Dnajb chaperone subfamily with HDAC-dependent activities suppresses toxic protein aggregation. Mol Cell 2010, 37, 355–369. [Google Scholar] [CrossRef] [PubMed]
- Månsson, C.; Kakkar, V.; Monsellier, E.; Sourigues, Y.; Härmark, J.; Kampinga, H.H.; Melki, R.; Emanuelsson, C. Dnajb6 is a peptide-binding chaperone which can suppress amyloid fibrillation of polyglutamine peptides at substoichiometric molar ratios. Cell Stress Chaperones 2014, 19, 227–239. [Google Scholar] [CrossRef] [PubMed]
- Mansson, C.; van Cruchten, R.T.P.; Weininger, U.; Yang, X.; Cukalevski, R.; Arosio, P.; Dovson, C.M.; Knowles, T.; Akke, M.; Linse, S.; et al. Conserved S/T residues of the human chaperone Dnajb6 are required for effective inhibition of abeta-42 amyloid fibril formation. Biochemistry 2018, 57, 4891–4902. [Google Scholar] [CrossRef] [PubMed]
- Reidy, M.; Sharma, R.; Roberts, B.-L.; Masison, D.C. Human J-protein Dnajb6b cures a subset of Saccharomyces cerevisiae prions and selectively blocks assembly of structurally related amyloids. J. Biol. Chem. 2016, 291, 4035–4047. [Google Scholar] [CrossRef] [PubMed]
- Cawood, E.E.; Clore, G.M.; Karamanos, T.K. Microsecond backbone motions modulate the oligomerization of the Dnajb6 chaperone. Angew. Chem. Int. Ed. 2022, 61, e202116403. [Google Scholar] [CrossRef]
- Kakkar, V.; Månsson, C.; de Mattos, E.P.d.; Bergink, S.; Zwaag, M.v.; Waarde, M.A.W.H.v.; Kloosterhuis, N.J.; Melki, R.; Cruchten, R.T.P.v.; Al-Karadaghi, S.; et al. The S/T-rich motif in the Dnajb6 chaperone delays polyglutamine aggregation and the onset of disease in a mouse model. Mol. Cell 2016, 62, 272–283. [Google Scholar] [CrossRef]
- Aprile, F.A.; Källstig, E.; Limorenko, G.; Vendruscolo, M.; Ron, D.; Hansen, C. The molecular chaperones Dnajb6 and hsp70 cooperate to suppress α-synuclein aggregation. Sci. Rep. 2017, 7, 9039. [Google Scholar] [CrossRef]
- Park, S.-K.; Hong, J.Y.; Arslan, F.; Kanneganti, V.; Patel, B.; Tietsort, A.; Tank, E.M.H.; Li, X.; Barmada, S.J.; Liebman, S.W. Overexpression of the essential Sis1 chaperone reduces TDP-43 effects on toxicity and proteolysis. PLoS Genet. 2017, 13, e1006805. [Google Scholar] [CrossRef]
- Meriin, A.B.; Zhang, X.; He, X.; Newnam, G.P.; Chernoff, Y.O.L.; Sherman, M.Y. Huntington toxicity in yeast model depends on polyglutamine aggregation mediated by a prion-like protein Rnq1. J. Cell Biol. 2002, 157, 997–1004. [Google Scholar] [CrossRef]
- Gokhale, K.C.; Newnam, G.P.; Sherman, M.Y.; Chernoff, Y.O. Modulation of prion-dependent polyglutamine aggregation and toxicity by chaperone proteins in the yeast model. J. Biol. Chem. 2005, 280, 22809–22818. [Google Scholar] [CrossRef]
- Zhao, X.; Park, Y.-N.; Todor, H.; Moomau, C.; Masison, D.; Eisenberg, E.; Greene, L.E. Sequestration of Sup35 by aggregates of huntingtin fragments causes toxicity of [PSI+] yeast. J. Biol. Chem. 2012, 287, 23346–23355. [Google Scholar] [CrossRef] [PubMed]
- Gong, H.; Romanova, N.V.; Allen, K.D.; Chandramowlishwaran, P.; Gokhale, K.; Newnam, G.P.; Mieczkowski, P.; Sherman, M.Y.; Chernoff, Y.O. Polyglutamine toxicity is controlled by prion composition and gene dosage in yeast. PLoS Genet. 2012, 8, e1002634. [Google Scholar] [CrossRef] [PubMed]
- Kochneva-Pervukhova, N.V.; Alexandrov, A.I.; Ter-Avanesyan, M.D. Amyloid-mediated sequestration of essential proteins contributes to mutant huntingtin toxicity in yeast. PLoS ONE 2012, 7, e29832. [Google Scholar] [CrossRef] [PubMed][Green Version]
- Kumar, J.; Kline, N.L.; Masison, D.C. Human Dnajb6 antiamyloid chaperone protects yeast from polyglutamine toxicity separately from spatial segregation of aggregates. Mol. Cell. Biol. 2018, 38, e004372013-18. [Google Scholar] [CrossRef] [PubMed]
- Song, Y.; Wu, Y.-x.; Jung, G.; Tutar, Y.; Eisenberg, E.; Greene, L.E.; Masison, D.C. Role for Hsp70 chaperone in Saccharomyces cerevisiae prion seed replication. Eukaryot. Cell 2005, 4, 289–297. [Google Scholar] [CrossRef] [PubMed]
- Sikorski, R.S.; Hieter, P. A system of shuttle vectors and yeast host strains designed for efficient manipulation of DNA in Saccharomyces cerevisiae. Genetics 1989, 122, 19–27. [Google Scholar] [CrossRef] [PubMed]
- Yan, W.; Craig, E.A. The glycine-phenylalanine-rich region determines the specificity of the yeast Hsp40 Sis1. Mol. Cell. Biol. 1999, 19, 7751–7758. [Google Scholar] [CrossRef] [PubMed]
- Reidy, M.; Sharma, R.; Shastry, S.; Roberts, B.-L.; Albino-Flores, I.; Wickner, S.; Masison, D.C. Hsp40s specify functions of Hsp104 and Hsp90 protein chaperone machines. PLoS Genet. 2014, 10, e1004720. [Google Scholar] [CrossRef]
- Sherman, F. Getting started with yeast. Methods Enzymol. 2002, 350, 3–41. [Google Scholar]
- Masison, D.C.; Maddelein, M.-L.; Wickner, R.B. The prion model for [URE3] of yeast: Spontaneous generation and requirements for propagation. Proc. Natl. Acad. Sci. USA 1997, 94, 12503–12508. [Google Scholar] [CrossRef]
- Suh, W.C.; Burkholder, W.F.; Lu, C.Z.; Zhao, X.; Gottesman, M.E.; Gross, C.A. Interaction of the Hsp70 molecular chaperone, Dnak, with its cochaperone Dnaj. Proc. Natl. Acad. Sci. USA 1998, 95, 15223–15228. [Google Scholar] [CrossRef] [PubMed]
- Greene, L.E.; Park, Y.-N.; Masison, D.C.; Eisenberg, E. Application of GFP-labeling to study prions in yeast. Protein Pept. Lett. 2009, 16, 635–641. [Google Scholar] [CrossRef] [PubMed][Green Version]
- Satpute-Krishnan, P.; Serio, T.R. Prion protein remodeling confers an immediate phenotypic switch. Nature 2005, 437, 262–265. [Google Scholar] [CrossRef] [PubMed]
- Miller, S.C.; Wegrzynowicz, A.K.; Cole, S.J.C.; Hayward, R.E.; Ganser, S.J.; Hines, J.K. Hsp40/JDP requirements for the propagation of synthetic yeast prions. Viruses 2022, 14, 2160. [Google Scholar] [CrossRef] [PubMed]
- Söderberg, C.A.G.; Månsson, C.; Bernfur, K.; Rutsdottir, G.; Härmark, J.; Rajan, S.; Al-Karadaghi, S.; Rasmussen, M.; Höjrup, P.; Hebert, H.; et al. Structural modelling of the Dnajb6 oligomeric chaperone shows a peptide-binding cleft lined with conserved S/T-residues at the dimer interface. Sci. Rep. 2018, 8, 5199. [Google Scholar] [CrossRef]

| Plasmid | Marker | Promoter | Protein Expressed | Source |
|---|---|---|---|---|
| pRS314 | TRP1 | na | empty vector | [36] |
| pRS315 | LEU2 | na | empty vector | [36] |
| pYW17 | URA3 | SIS1 | Sis1 | [37] |
| pMR286 | TRP1 | GPD | Sis1-cmyc | [38] |
| pMR286DN | TRP1 | GPD | Sis1D36N-cmyc | [38] |
| pRED156 | URA3 | TETr | Sis1 | This study |
| pMR266 | TRP1 | GPD | Sis1 | [24] |
| pMR266DN | TRP1 | GPD | Sis1D36N | [24] |
| JE167 | LEU2 | GPD | Sis1-mCh | [19] |
| JE167DN | LEU2 | GPD | Sis1D36N-mCh | This Study |
| JE237 | LEU2 | SIS1 | Sis1JGF | This Study |
| JE65 | TRP1 | SIS1 | Sis1JGF | This Study |
| pMR328 | TRP1 | GPD | DnaJB6b-cmyc | [24] |
| pMR328DN | TRP1 | GPD | DnaJB6bD33N-cmyc | [24] |
| pRED155 | TRP1 | GPD | DnaJB6b∆ST | [24] |
| pMR399 | TRP1 | GPD | DnaJB6b | This study |
| pRED152 | TRP1 | GPD | DnaJB6b-mCh | This Study |
| pRED152DN | TRP1 | GPD | DnaJB6bD33N-mCh | This Study |
| pRU14 | LEU2 | GAL | DnaJB6b | [24] |
| pRED114 | TRP1 | GAL | DnaJB6b | This study |
| JE66 | TRP1 | SIS1 | Sis1 | [19] |
| JE239 | TRP1 | SIS1 | Sis1 | [19] |
| pRED144 | TRP1 | GPD | DnaJB6b-STC | This Study |
| pRED142 | TRP1 | GPD | DnaJB6b-ST | This Study |
| pRED155 | TRP1 | GPD | DnaJB6b∆ST | This Study |
| pMR329 | TRP1 | GPD | DnaJB6b∆STCTD | [24] |
| Test Protein | Doubling Time (min) | |
|---|---|---|
| [psi−] | [PSI+]S | |
| Sis1 | 195 ± 5 | 225 ± 7 |
| ev (JGF only) | 270 ± 10 | inviable |
| JB6 | 315 ± 5 | 520 ± 42 |
| JB6-D33N | 285 ± 15 | 455 ± 7 |
Publisher’s Note: MDPI stays neutral with regard to jurisdictional claims in published maps and institutional affiliations. |
© 2022 by the authors. Licensee MDPI, Basel, Switzerland. This article is an open access article distributed under the terms and conditions of the Creative Commons Attribution (CC BY) license (https://creativecommons.org/licenses/by/4.0/).
Share and Cite
Dolder, R.E., III; Kumar, J.; Reidy, M.; Masison, D.C. Human J-Domain Protein DnaJB6 Protects Yeast from [PSI+] Prion Toxicity. Biology 2022, 11, 1846. https://doi.org/10.3390/biology11121846
Dolder RE III, Kumar J, Reidy M, Masison DC. Human J-Domain Protein DnaJB6 Protects Yeast from [PSI+] Prion Toxicity. Biology. 2022; 11(12):1846. https://doi.org/10.3390/biology11121846
Chicago/Turabian StyleDolder, Richard E., III, Jyotsna Kumar, Michael Reidy, and Daniel C. Masison. 2022. "Human J-Domain Protein DnaJB6 Protects Yeast from [PSI+] Prion Toxicity" Biology 11, no. 12: 1846. https://doi.org/10.3390/biology11121846
APA StyleDolder, R. E., III, Kumar, J., Reidy, M., & Masison, D. C. (2022). Human J-Domain Protein DnaJB6 Protects Yeast from [PSI+] Prion Toxicity. Biology, 11(12), 1846. https://doi.org/10.3390/biology11121846
